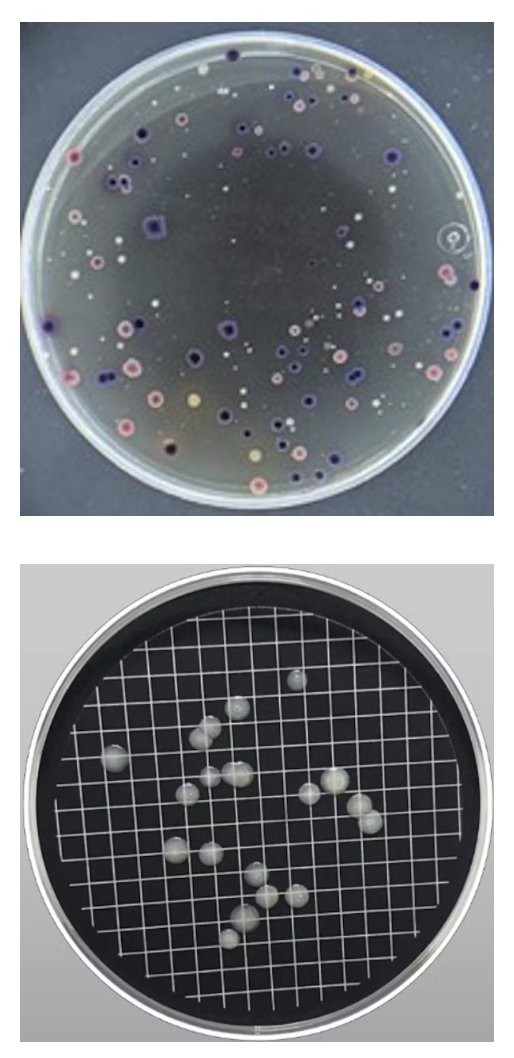
patogenos

El cambio climático favorece el crecimiento de microorganismos patógenos que pueden llegar a nuestros grifos
- 395 lecturas
Cada vez que abrimos el grifo de casa, ni siquiera nos planteamos si el agua que sale es segura. Si la vemos transparente y no huele mal parece que es suficiente. Solo cuando vamos de viaje, dependiendo de cuál sea el destino, nos surgen dudas. La culpa la tienen algunos microorganismos patógenos que pueden vivir y desarrollarse libremente en ella. El problema es que no los vemos a simple vista, pero están ahí.
Después de muchos años trabajando con estos diminutos seres, en mi último estudio he mostrado su impacto en la salud pública debido a su cada vez más frecuente proliferación en el agua de consumo y su relación con los eventos climáticos extremos derivados del cambio climático.
Cuando se rompe el equilibrio
Los microorganismos ocupan extensas regiones de la Tierra debido a su facilidad para adaptarse incluso a las condiciones ambientales más adversas. Su mera presencia en el agua de consumo no indica que sean un riesgo para la salud humana, incluso aunque se encuentren en cantidades muy elevadas.
El problema aparece cuando se multiplican y diseminan sin control y aparecen microorganismos patógenos que deterioran la calidad del agua, dando lugar a olor y sabor desagradables y causando enfermedades que pueden llegar a ser letales.
Bacterias, virus y protozoos son los microorganismos que con más frecuencia se han identificado en las aguas de consumo, junto con las endotoxinas de algunas cianobacterias.
Escherichia coli, Salmonella, Vibrio, Legionella, helmintos (gusanos parásitos), virus causantes de la hepatitis, cianobacterias y un largo etcétera son algunas de estas amenazas invisibles. Y no solo pueden infectar por la ingesta provocando enfermedades gastrointestinales, sino también a través de la piel o en forma de aerosol llegando a nuestros pulmones como es el caso de la Legionella.
Asimismo, las toxinas generadas por las cianobacterias o algas verde-azuladas cada vez son más abundantes en las fuentes de suministro de agua cuya temperatura está por encima de 20 ºC. Esto limita la disponibilidad de agua para consumo humano debido a su dificultad para ser eliminadas en los sistemas de potabilización.
Floración de algas verde-azuladas en el lago Erie en Estados Unidos. NASA Earth Observatory. Landsat 5. CC BY-SA
El reto del cambio climático
El cambio climático supone un auténtico desafío. La temperatura de la Tierra se ha incrementado en más de 1 ºC en las últimas décadas y esa tendencia es cada vez más acusada, tal y como se ve reflejado en los datos de satélite recogidos por la NOAA.
El aumento de la temperatura promueve el crecimiento, la resiliencia y la dispersión de los microorganismos. Pero no solo eso, también es responsable de los fenómenos meteorológicos extremos cada vez más frecuentes.
Las inundaciones provocan la circulación de grandes volúmenes de agua por el terreno, arrastrando nutrientes y contaminando las aguas superficiales. Por su parte, las sequías pueden ocasionar un empeoramiento de las condiciones sanitarias y una alta concentración de nutrientes que pueden llegar hasta las aguas subterráneas.
Todo esto proporciona a los microorganismos las condiciones ideales para multiplicarse y diseminarse. Además, los agentes desinfectantes pierden eficacia ante el aumento de las temperaturas, cada vez más extremo y persistente.
Muchas epidemias derivadas de patógenos en aguas potables tienen lugar después de periodos de inundaciones, como los identificados en el agua de consumo de la Comunidad Valenciana (España) tras el paso de una fuerte dana en octubre de 2024.
Microorganismos que se multiplican exponencialmente
Incluso en los países desarrollados, con estrictos controles y regulaciones, hay muchos puntos críticos, desde el abastecimiento de agua hasta nuestro grifo. Esto hace que, ante situaciones climáticas extremas, los microorganismos se multipliquen exponencialmente y tengan acceso a la red de suministro.
Crecimiento de colonias azules de Escherichia coli en la imagen de arriba y de Legionella pneumophila en la de abajo. Ambos casos proceden de muestras de agua de consumo. Ana Pérez Gimeno
El Centro Europeo de Prevención y Control de Enfermedades (ECDC) hace un seguimiento de los brotes epidemiológicos que periódicamente se dan y busca el origen para poder combatirlos. Son frecuentes las enfermedades gastrointestinales en verano, causadas por la ingesta de agua contaminada por las bacterias Escherichia coli, Salmonella, Vibrio o Campylobacter.
Si se hace un estudio de la evolución de los casos de legionelosis en la Unión Europea, se observa un evidente aumento en los últimos años, siendo los países más afectados Italia, Francia, Alemania y España. Estos países han experimentado veranos muy calurosos, de entre 35-40 ºC, y elevados índices de humedad, proporcionando las óptimas condiciones para el crecimiento y dispersión de la bacteria Legionela.
Cómo afrontar el desafío
La contaminación microbiológica es un reto, tanto en países desarrollados como en vías de desarrollo, agravado por el calentamiento global. La crisis climática nos obliga a mirar el agua potable no solo en términos de cantidad, sino también de calidad.
Por tanto, es necesario entender que la salud de nuestras aguas empieza por minimizar los efectos derivados del cambio climático. Hay que establecer una legislación global que regule los protocolos de vigilancia y control y construir infraestructuras resilientes a los fenómenos meteorológicos extremos.
Un ejemplo de la efectividad de este tipo de medidas fue la drástica disminución de los casos notificados de microorganismos en aguas de consumo en 2020, lo que se atribuye a los estrictos controles y protocolos higiénicos derivados de la epidemia mundial de covid-19. Fue un punto de inflexión en el desarrollo de procedimientos de análisis rápidos y precisos para identificar los habitantes invisibles de las aguas y así poder controlarlos y eliminarlos antes de su llegada a nuestro grifo.
![]()
Un artículo de Ana Pérez Gimeno, Profesor Ayudante Doctor en el Área de Ingeniería Química, Universidad Miguel Hernández


